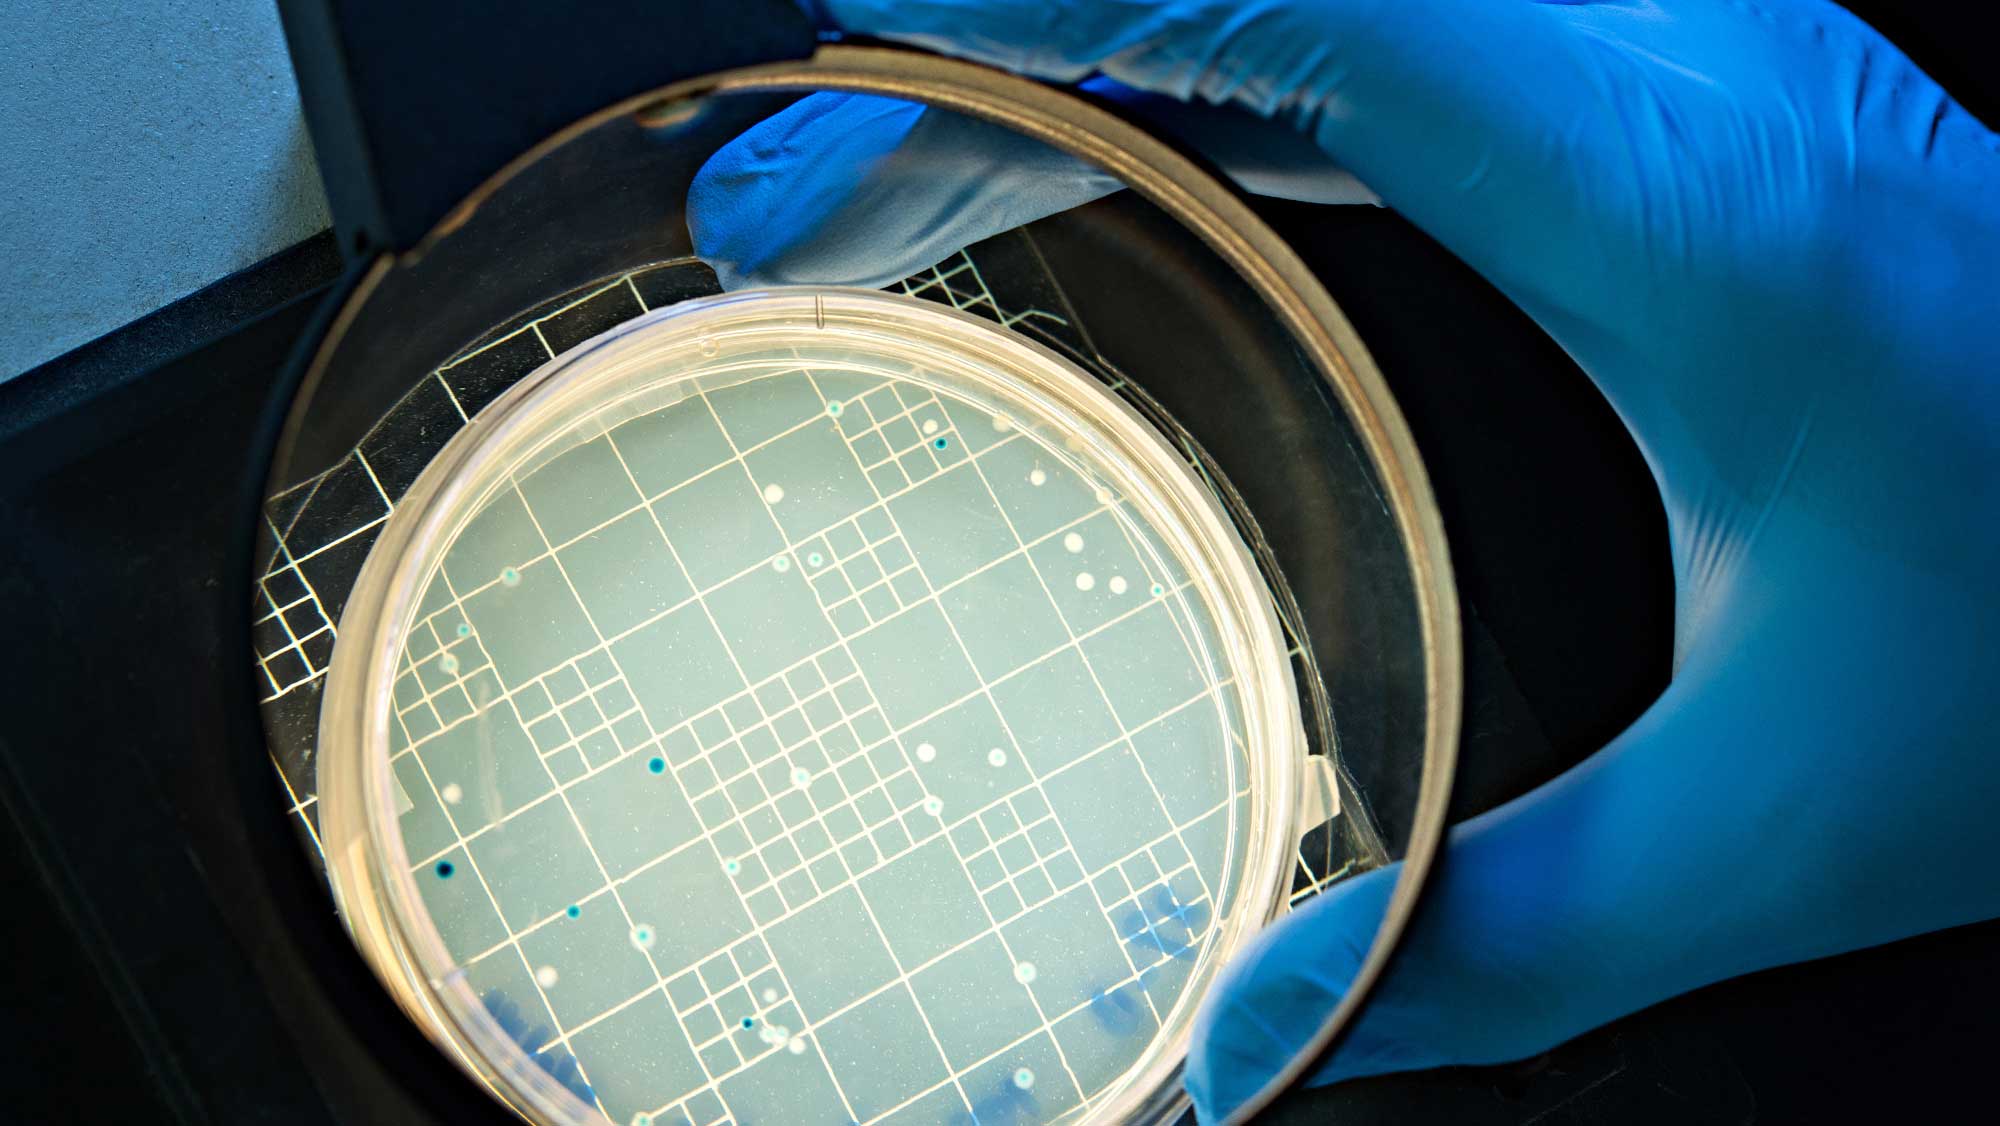

Our faculty and students conduct research that improves quality of life worldwide.
Using satellite data, researchers estimated the storage capacity of over 7,000 global reservoirs from 1999 to 2018 and discovered while the total capacity has increased, the filling rate is lower than expected.

Researchers are applying artificial intelligence techniques to design and operate energy-efficient district heat pump systems that serve human needs and behaviors while reducing the carbon footprint of buildings.

Researchers discovered a groundbreaking 1,000% increase in the storage capacity of water-based battery electrodes. This research is a step toward lithium-free batteries, allowing for better control over the domestic supply chain.

Research conducted by higher education has made a significant impact on our health, safety and quality of life, and has contributed to the economic growth and development of our country.
The College of Engineering — through its affiliation with the德州农工大学工程实验and with partnerships with industry and other institutions of higher education — is committed to helping keep our country competitive by conducting practical research to address world problems.
Dr. Prabhaker Pagilla, associate dean for research
Phone:979-458-4829 |Email:ppagilla@tamu.edu